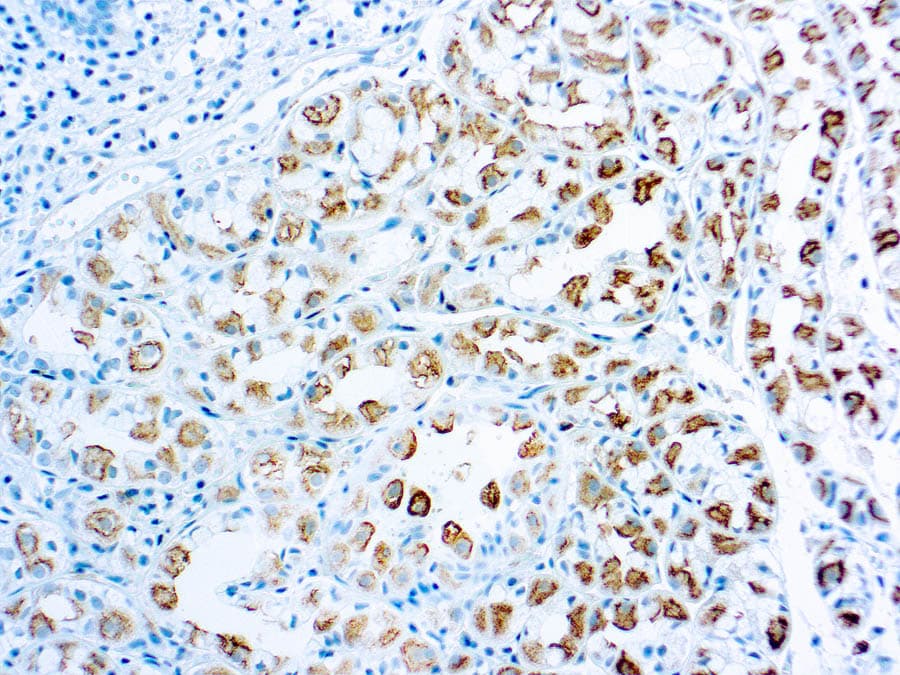

Anti-Survivin CE/IVD para IHC - Patología pediátrica
La survivina (IAP4) es el miembro más pequeño de la familia de genes de la proteína inhibidora de la apoptosis (IAP). Las IAP están implicadas en múltiples funciones celulares, como la señalización celular, la división celular y el metabolismo, y presentan una expresión diferencial en casi todos los cánceres humanos, pero no en la mayoría de los tejidos normales. Los miembros de la familia IAP suelen contener múltiples dominios de repetición IAP de baculovirus (BIR), pero el gen Survivin codifica proteínas con un solo dominio BIR. La Survivina es casi indetectable en células terminalmente diferenciadas, pero se encuentra en la mayoría de los tumores, incluidos el carcinoma de células renales, el carcinoma de ovario, el carcinoma hepatocelular, el carcinoma de próstata y el carcinoma de mama. La expresión de survivina está relacionada con la progresión tumoral, pero no con la supervivencia de los pacientes. La sobreexpresión de survivina en el cáncer puede superar este punto de control apoptótico y favorecer la progresión aberrante de las células transformadas a través de la mitosis.
Resultados de su búsqueda : 3 Producto encontrado
Refine su búsqueda :
- Unconjugated 3
- human 3
- mouse 3
- Primary antibody
- IHC 3
- IHC668 3
